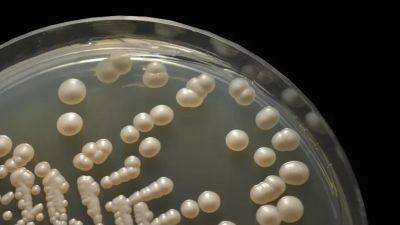

Дрожжи Кандида

💣 👉🏻👉🏻👉🏻 ИНФОРМАЦИЯ ДОСТУПНА ЗДЕСЬ! КЛИКАЙ 👈🏻👈🏻👈🏻
Дрожжи против кандидоза - Здоровье и гигиена
Дрожжи, разрaстание кандиды . . . Противокандидная диета и . . .
Пищевые дрожжи и Кандида
Дрожжевой грибок кандида у женщин: лечение, причины и . . .
Грибок КАНДИДА: симптомы, лечение,диета .Кандида и аутизм . . .
Дрожжи кандида в желудке
Дрожжи кандида в кишечнике лечение
Дрожжи в мазке: почему появляются и как лечить
Дрожжи: действие на организм, польза и вред | Food and Health
Дрожжи кандида в результате гастроскопии - Вопрос . . .
Препарат Депакин Хроно 500
Гибкие Связи Для Кладки Гален
Декарис Схема Чичагова
Кандида — это грибок, разновидность дрожжей . Многие используют термины «переизбыток дрожжей» и «кандида» как взаимозаменямые .
Поговорим же мы более детально о кандиде . . .Кандида - это род дрожжей ( около 186 видов), часть из этих видов не является патогенной и отлично сосуществует с организмом хозяина . Многие из этих подвидов есть в микрофлоре ЖКТ человека и при симбиозе с другими культурами создают нормальную флору и здоровую среду .
Candida — болезнетворные дрожжи, которые могут вызвать проблемы, включая молочницу, вагинальный кандидоз и оральный кандидоз, если он становится запущенным . Пищевые дрожжи — это тип дезактивированных дрожжей, которые потребляются людьми, которые хотят добавить белки и витамины к своему рациону, таким как веганы и вегетарианцы .
Дрожжевой грибок кандида у женщин: лечение, причины и симптомы на фото Появление тревожных симптомов требует принятия срочных мер - обращения к врачу .
Грибок Candida (кандида): симптомы, лечение, диета Кандида (Candida) - это род дрожжей из царства грибов Они, равно как и другие микроорганизмы, мирно обитают в организме здорового человека - в полости рта, во влагалище и в . . .
Дрожжи кандида в . . . В небольшом количестве дрожжеподобные грибки рода Кандида присутствуют в организме любого человека .
Кандидоз пищевода, желудка и кишечника Весь контент iLive проверяется медицинскими экспертами, чтобы обеспечить максимально возможную точность и
Дрожжи в мазке при беременности Кандиды не опасны для беременной женщины и её ребенка . Но урогенитальный кандидоз неприятен, так как сопровождается зачастую выраженной симптоматикой . Поэтому в случае обнаружения дрожжей в мазке лечение назначают на любых сроках беременности . Его проводят препаратами местного действия .
Кандида, как и все дрожжи, одноклеточный организм, который быстро размножается при наличии большого количества сахара в рационе . Этот грибок лишает организм многих питательных веществ, в том числе железа и других минералов, делая кровь кислой . На фоне сладкого . . .
Цитология: слизь, детрит, лейкоциты 8-9 в п/зр ., клетки и группы клеток железистого эпителия . АК не найдены . Хеликобактер - умеренно . Флора - кокки большое кол-во, дрожжи кандида местами скопления .
Кромицил Глазные Капли Отзывы
Мирена Изготовитель
Жанин Когда Начинать
Детралекс 100
Гризеофульвин Таблетки Для Чего Применяют
После Цитофлавина Хочется Спать
Випросал При Гв
Антидот Бупивакаина
Метрогил Для Век
Ярина Плюс 28х3
Эноксапарин 0 6 Цена
Пробиотик Максилак
Дексилант Нольпаза
Цефтриаксон Цена Фото
Супрадин Кидс 60 Таблеток Цена
Польза Коэнзима Q10 Для Женщин Мнение Врачей
Ирс 19 Минск
Флуконазол Способ Применения
Отзывы Цинкита Для Волос
Фосфоглив И Эссенциале В Чем Разница
Эутирокс Или Эльтероксин Что Лучше
Клацид Какая Группа
Энтеросгель Для Чего Применяется
Элидел На Лицо Отзывы
Кеналог Блокада Отзывы
Мемантин Рихтер 10 Мг 60 Таблеток Цена
Фолиевая Кислота В6
Капли Визин Линзы
Вазобрал За И Против
Но Шпа При Цистите У Детей
Тонзилгон Месячному Ребенку
Пентоксифиллин Внутривенно Инструкция По Применению Цена
Назонекс При Храпе У Ребенка
Хондрогард 200 Цена
Генферон Капли Спрей
Форсига Цена В Новосибирске Дешево
Город Мирный Вч
Моксонидин Уколы Цена
Физиомер Спрей Назальный Гипертонический
Гриппферон Капли От Заложенности Носа Отзывы
Рокс С Кальцием Для Детей
Супрадин Волшебные Драже 90 Цена
Немозол Против Чего
Зенон Краснодар Телефон
Сульфадиметоксин Отзывы
Терафлекс Крем Применение Цена
Кап Флуконазол 150 Мг Цена
Релиф Терапия В Психологии
Конвалис Фото
Мильгамма N10 Уколы Цена
Колдакт Флю Капсулы Цена
Ретиналамин Аптека Ру Петрозаводск
Препарат От Вируса Осельтамивир
Механизм Бронхолитического Действия Эуфиллина
Ципролет Калининград
Применение Геля Венолайф
Омизак
Таблетки От Горла Максиколд Лор
Полисорб Показания И Противопоказания К Применению
Форадил Саратов
4 Таблетки Каптоприла
Бисептол Суспензия Доза
Маска Для Волос С Пиридоксином
Инструкция Применения Циклоферона При Гриппе
Ингалипт При Грудном Вскармливании
Габапентин Канон 300 Курс Приема
Преднизолон При Неврите Отзывы
Капли В Глаза Тимолол Инструкция По Применению
Экстракт Элеутерококка Инструкция По Применению Отзывы
Энтеросгель Инструкция Детям 8 Лет
Элоком Лосьон В Ульяновске
Эйсипи Собака
Бронхипрет Цена Максавит
Крем Ретинол Весна
Миндалины Связь
Отзывы Препарата Вилдегра
От Эриуса Зуд
Тобрадекс Капли Инструкция Детям
Ирунин Таблетки Отзывы От Молочницы И Кандидоза
Офломелид Анальная Трещина Форум
Мукалтин От Сухого Кашля
Интерферон Альфа 2 Д
Церебролизин 5 Мл Отзывы
Синекод Применение
Каптоприл Сандоз 25 Отзывы
Дермовейт Мазь Цена СПб
Велсон От Бессонницы
Нафтодерил Раствор От Грибка Ногтей Цена
Аналоги Стрепсилс От Горла Дешевые
Вигантол Стоимость В Аптеках
Лонгидаза Колоть Через День
Деринат При Геморрое
Но Шпа От Каких Видов Боли
Какой Перерыв Между Пентаксимом
Свечи С Календулой
Евпатория Аптека Ру Нефростен Цена
Супракс 400 7шт
Настойка Боярышника И Корвалол
Прием Сиофора Для Похудения
Конвулекс Эффект
Дрожжи Кандида

.jpg)



































